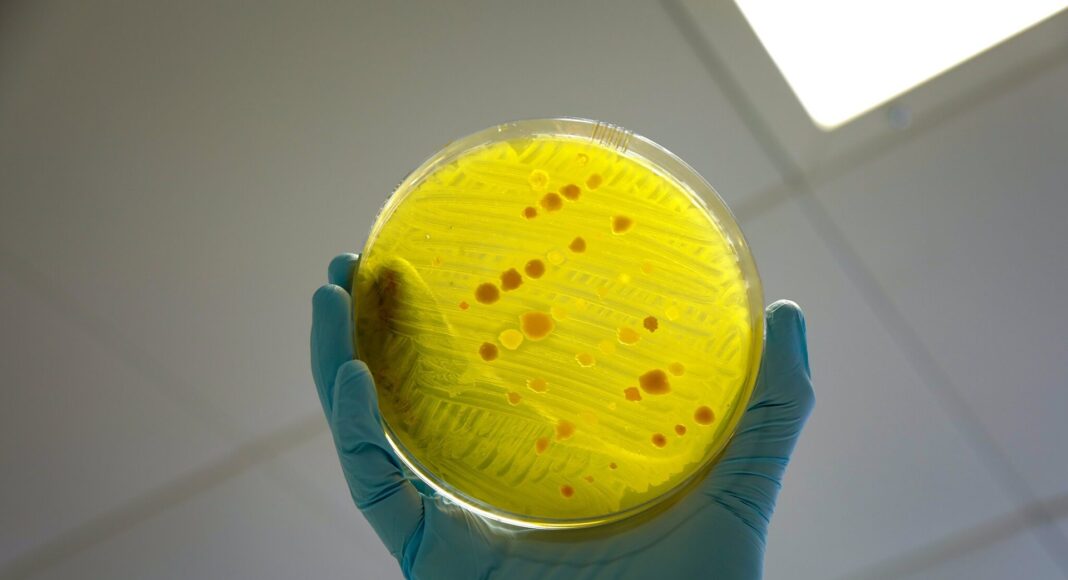

Μια σημαντική ανακάλυψη για τον τρόπο με τον οποίο τα βακτήρια αναπτύσσουν αντοχή στα κοινά αντιβιοτικά θα μπορούσε να ανοίξει τον δρόμο για πιο αποτελεσματικές θεραπείες απέναντι στις ανθεκτικές λοιμώξεις, σύμφωνα με νέα μελέτη.
Eρευνητές από το Πανεπιστήμιο του Εδιμβούργου διαπίστωσαν ότι η στοχευμένη αντιμετώπιση ενός συγκεκριμένου μηχανισμού άμυνας των βακτηρίων θα μπορούσε να ενισχύσει ουσιαστικά τη μάχη κατά της μικροβιακής αντοχής – μιας από τις πιο επικίνδυνες και ταχέως αυξανόμενες απειλές για τη δημόσια υγεία παγκοσμίως.
Συγκεκριμένα, η ερευνητική ομάδα μελέτησε ένα σύστημα επιδιόρθωσης, γνωστό ως Rtc, το οποίο διαθέτουν ορισμένα βακτήρια για να αντιμετωπίζουν τις επιδράσεις συγκεκριμένων αντιβιοτικών. Το σύστημα αυτό λειτουργεί επιδιορθώνοντας το RNA — το κρίσιμο μόριο που είναι υπεύθυνο για τη μετάφραση της γενετικής πληροφορίας σε λειτουργικές πρωτεΐνες μέσα στα κύτταρα. Με τη διατήρηση της παραγωγής πρωτεϊνών και της κυτταρικής ανάπτυξης, το Rtc επιτρέπει στα βακτήρια να επιβιώνουν ακόμη και υπό την επίδραση αντιβιοτικών.
Ένα βασικό εύρημα της μελέτης ήταν η απρόβλεπτη φύση της βακτηριακής αντίδρασης στα αντιβιοτικά, που φαίνεται να οφείλεται στις διαφορές στην ενεργοποίηση του συστήματος Rtc από κύτταρο σε κύτταρο. Το εύρημα αυτό υποδηλώνει ότι, αν οι θεραπείες σχεδιαστούν ώστε να στοχεύουν συγκεκριμένα συστατικά του συστήματος Rtc, θα μπορούσαν να ενισχύσουν την αποτελεσματικότητα των υπαρχόντων αντιβιοτικών και να τα καταστήσουν πιο ικανά να εξαλείψουν τις λοιμώξεις. Η ανακάλυψη προέκυψε μέσω συνδυασμού υπολογιστικής μοντελοποίησης και εργαστηριακών πειραμάτων, στα οποία χρησιμοποιήθηκε το βακτήριο E. coli, γνωστό για την ικανότητά του να αναπτύσσει αντοχή στα αντιβιοτικά.
Η Δρ. Άντρεα Βάις, από τα Τμήματα Βιολογικών Επιστημών και Πληροφορικής του Πανεπιστημίου του Εδιμβούργου, η οποία ηγήθηκε της έρευνας, τόνισε την επείγουσα ανάγκη για νέες προσεγγίσεις.
«Τα βακτήρια είναι έξυπνοι μικροί οργανισμοί. Μαθαίνουν συνεχώς πώς να αποφεύγουν τα αντιβιοτικά μας — και γίνονται ολοένα καλύτερα σε αυτό», δήλωσε.
«Αν δεν βρούμε νέα φάρμακα ή νέους τρόπους να τα ξεγελάσουμε, θα έχουμε τεράστιο πρόβλημα. Αυτό που προσπαθούμε να κάνουμε είναι να κατανοήσουμε πώς λειτουργούν οι αμυντικοί τους μηχανισμοί. Μόλις κατανοήσουμε πλήρως τον μηχανισμό, θα μπορέσουμε να βρούμε πιο έξυπνους τρόπους για να τους νικήσουμε και να αντιμετωπίσουμε τις λοιμώξεις πιο αποτελεσματικά» σημείωσε.
Τα ευρήματα της μελέτης δημοσιεύθηκαν στο επιστημονικό περιοδικό Nature Communications.
ΠΗΓΗ: Independent